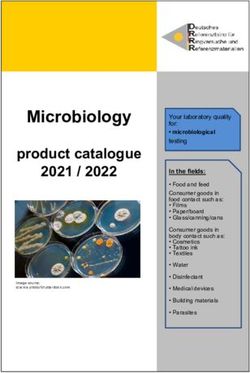
Microbiology product catalogue 2021 / 2022 - DRRR.de

MEAT SOURCING GLOBAL INVESTOR ENGAGEMENT ON - Engaging QSRs on climate and water risks to protein supply chains - Ceres
←
→
Page content transcription
If your browser does not render page correctly, please read the page content below
G LO B A L I N V E S TO R E N G AG E M E N T O N M E AT SOU RCI N G Engaging QSRs on climate and water risks to protein supply chains P R O G R E S S B R I E F I N G • A P R I L 2 0 2 1 1
Executive summary
The Global Investor Engagement on Meat However, progress towards mitigating risks related
Sourcing, initiated in 2019, consists of dialogues to water scarcity and pollution has been limited.
between six of the largest quick-service restaurant In addition, only two of the six companies have
(QSR) brands and institutional investors with over disclosed plans to conduct a 2°C scenario analysis, a
$11 trillion in combined assets. Investors have urged key recommendation of the Task Force on Climate-
the QSRs to analyse and reduce their vulnerability Related Financial Disclosures (TCFD). While the
to the impacts of climate change, water scarcity, progress to date is encouraging, there are critical
and pervasive threats to water quality driven by elements yet to be addressed around climate and
animal protein production. water-related financial risks.
Companies have made notable progress in
addressing these concerns. All six target companies
have now publicly stated they will set or have
already set global GHG reduction targets. Five of
the six QSRs have now set or committed to setting
emissions reduction targets approved by the
Science-Based Targets initiative (SBTi) that would
align their businesses with the Paris Agreement’s goal
to limit global temperature rises to well below 2°C.
2Contents
The case for engagement 4
Trends in company performance 6
Board oversight and ESG risk
management capacity 6
Emissions reduction targets 7
TCFD-aligned scenario analysis 9
Supply chain water use and quality 11
Supplier policies 12
Evaluation framework to assess 13
risk management
Company benchmarking 14
Next steps for engagement 15
Supply chain water use and quality 15
TCFD-aligned scenario analysis 15
3The case for engagement
Prior to the start of this engagement in 2019, many institutional The US does not yet have binding regulations on reporting
investors had come to appreciate the materiality of climate climate risks, but calls for regulatory advancements are
and water risks posed to quick-service restaurants through growing. The US Commodity Futures Trading Commission’s
their livestock supply chains. More details on the business risks Market Risk Advisory Committee (MRAC) released a report
to QSRs associated with these environmental threats can be detailing 53 recommendations to mitigate climate risks to the
found in the engagement’s January 2020 Progress Briefing and financial system. Noting that climate change presents “a major
the sample letter sent to companies by this investor coalition in risk to the stability of the US financial system”, the report
2019. In 2020, we saw an increasing number of calls for enhanced recommends that US regulators must “move urgently and
climate change-related disclosures and new academic evidence decisively to measure, understand, and address these risks”
underscoring the materiality of these issues to the meat and that the finance industry must direct capital towards
sourcing value chain. accelerating the net-zero transition.3 The US Federal Reserve has
acknowledged that climate change increases financial stability
Investors are increasingly adopting ambitious climate change
risks and is calling for increased disclosure against these risks, as
targets and are engaging with portfolio companies on plans
well as further research to help incorporate climate risks into
to align with limiting warming to 1.5 degrees celsius. The
financial stability monitoring.4
investor participants in the Net Zero Asset Owners Alliance and
Net Zero Asset Managers Initiative have committed to supporting New environmental regulations directly impacting the
the goal of net-zero greenhouse gas emissions by 2050, in line with livestock industry may increase operational costs and disrupt
global efforts to meet the Paris Agreement; and to supporting protein producers’ business models, increasing risk to quick-
investing aligned with net-zero emissions by 2050. The targets service restaurant supply chains and potentially reducing
are increasingly becoming a priority for large, conventional asset profit margins. Water quality and quantity transition risks are
managers: these initiatives are supported by 33 investor signatories a significant concern. In the US, the Biden administration has
with $5.5 trillion in assets under management (AUM) and 87 signalled its intent to implement regulatory changes that could
signatories with $37 trillion in AUM respectively.1 directly impact meat supply chains.5 Biden’s $2 trillion climate
plan may include broader regulation and updated nationwide
New guidance and regulations to improve climate-related
standards, while increased enforcement of the Clean Water
disclosures and financial stability will likely continue to drive this
Act (CWA) – the primary federal law controlling and preventing
trend. In November 2020, the UK announced that companies will
water pollution in the US meat supply chains – could lead
be legally required to report on climate risks in line with the Task
to stricter effluent discharge guidelines and penalties for
Force on Climate-Related Disclosures (TCFD) recommendations
CWA violations at the factory farm level, causing a potential
by 2025. The new rules will apply to a wide range of companies,
increase in reputational and financial risk.6 QSRs could also face
including listed commercial companies, UK-registered large private
significant impacts from legislative reforms. For example, if
companies, banks, building societies, insurance companies, UK-
adopted the Farm System Reform Act (FSRA) would immediately
authorised asset managers, life insurers, FCA-regulated pension
prohibit the creation and expansion of concentrated
schemes and occupational pension schemes.2
animal feeding operations and require a total phase-out by
2040.7 Legislative proposals like the FSRA indicate that the
environmental impacts of large meat producers are drawing
more attention from lawmakers.
4Calls for a ‘meat tax’ have grown, especially in Europe. The While meat taxes are not yet a reality, some of the companies
tax would increase the price of livestock products. FAIRR’s in this engagement recognise this as a material transition risk.
report The Livestock Levy identifies several steps that led to McDonald’s identifies potential regulation impacting franchisees
the implementation of behavioural taxes on tobacco, carbon and suppliers as a climate-related risk that could increase raw
and sugar, and argues that the first step for a meat tax may have material costs, and is likely to emerge in the medium term.8
already been taken. Yum! Brands also recognises environmental regulation impacting
franchisees and suppliers as a material risk, but ranks this as a
Step 1: Scientific WHO’s International Agency for Research long-term, unlikely risk.9
evidence of negative on Cancer ranks processed meats as
societal impacts Group 1 carcinogens and identifies red meat There is mounting scientific research demonstrating the high
culminating in as a probable cause of cancer (2015). The environmental impact of meat and dairy products and the
international consensus, IPCC Special Report on Climate Change and vulnerability of livestock production to climate and water risk.
backed by a UN body. Land concludes that reductions in meat The latest academic work on this issue further underscores the
consumption and deforestation are likely to
impact these risks will have on the animal agriculture industry.
be required to solve the climate crisis.
A report issued in 2020 by the United Nations Environmental
Program Finance Initiative (UNEP FI) suggests that, under an
Step 2: A compelling Research by Oxford University concludes ambitious transition scenario, intensively grazed beef will have
financial public benefit that a health tax on red and processed the highest transition costs amongst the whole agricultural and
case to justify the meat could save over $40 billion in global forestry sector. The report suggests these costs will arise from
imposition of a tax. This healthcare costs (2018). tightly controlled land-use practices, carbon taxes, shifts to plant-
usually justifies cost
based diets, increases in meat substitutes, and rising prices for
incurred now (tax) to
avoid the risks of more
resource-intensive crops.10
severe consequences in A recent study from the University of Minnesota underscored
the future.
the meat supply chain’s vulnerability to water stress in North
Step 3: The emergence The case for whether a ‘meat tax’ would America. The analysis found that 78% of irrigated feed is
of evidence and/or result in the desired environmental and consolidated in just six companies. The study also found that the
political support that a health outcomes is unknown. largest meat companies have the highest proportion of their feed
tax can help lessen the sourced from areas facing chronic or seasonal water shortages.
societal/environmental National Beef, Cargill, JBS, Smithfield Foods and Tyson Foods all
harm being caused.
have over half of their feed sourced from these vulnerable areas.11
These companies are critical to the supply chains of the six focus
QSRs of this engagement.
Step 4: Current state Proposals for some form of ‘meat tax’
of taxation levels have been discussed in Sweden, Denmark,
Germany, New Zealand and the Netherlands.
Source: FAIRR Initiative (2020) “The Livestock Levy Progress Report”
5Trends in company performance
Board oversight and ESG risk management capacity
For the first time, all six companies now acknowledge the Companies have added internal staff capacity focused on managing
materiality of climate and water risks to their supply chains in ESG risks with a growing focus on meat and dairy supply chains.
their annual financial filings. This is an important step towards
• Wendy’s announced the completion of its ESG materiality
integrating sound management of these issues across their
assessment, pledging that the assessment would inform target
operations, and suggests that the companies will be dedicating
setting moving forward. The assessment labelled “Climate,
more resources to addressing these risks going forward.
Energy, & Water” among the most material topics to the
Companies are enhancing board oversight of sustainability company and stakeholders.14
broadly, but it remains unclear if climate and water risks
• Domino’s added internal sustainability-focused staff and
specific to livestock production are discussed on a regular
reported that it is “working with outside experts to determine
basis. Companies should disclose this information more widely,
[its] environmental baselines and developing initiatives to
and ensure that climate and water risks specific to protein supply
reduce [its] impact on the environment, including the impact
chains are a specific and formal agenda item for each board
of energy, waste water, land use and waste reduction, both in
meeting. Over the last year, progress in this area included:
[its] packaging and food.” 15
• In its 2021 proxy statement, Domino’s clarified that
• Chipotle became the first of the six QSRs to explicitly tie
environmental risks to its meat supply chain were regularly on
executive compensation to sustainability goals, including
its board’s agenda.
the company’s goal to measure its Scope 3 emissions by the
• McDonald’s Board of Directors includes a sustainability and end of 2021. The company also created an internal climate
corporate responsibility committee that has oversight of steering committee focused on curbing emissions and
climate and water commitments, among other issues. The managing climate risks.16
company disclosed to signatories how frequently its executive
team meets with this committee. Investors have encouraged
the company to disclose this information publicly.
Analysis of Chipotle’s Real FoodPrint tool
• RBI does not yet have a board committee focused on
sustainability or ESG risks. The company privately disclosed In 2020, Chipotle introduced a tool that lets customers
to signatories how frequently ESG is discussed at the board calculate the environmental impacts of their orders.
level. Investors have encouraged the company to disclose this Chipotle’s Real FoodPrint tool compares the carbon,
information publicly. water, soil health, land, and antibiotics footprints of its
ingredients to those of industry averages.
• In its CDP Climate Change report, Yum! Brands states that
the board is updated annually on ESG issues through its audit Despite the aim for transparency and an appeal to
committee, but does not specify whether livestock supply environmentally conscientious consumers, the framing of
chain risks in particular are discussed. the metrics belies the stark difference in the environmental
impacts of meat and vegetarian options. For example,
• Wendy’s Corporate Social Responsibility Committee
according to Real FoodPrint, ordering steak saves nearly 150
convened twice in 2020.12 The company specified that, among
mg of antibiotics, while selecting sofritas (tofu) saves 0 mg
other sustainability-related matters, the committee is tasked
of antibiotics – a misleading calculation as tofu does not
with reviewing risk management practices to “ensure a
require antibiotics to be produced. Additionally, the tool
sustainable and resilient supply chain.”13
asserts that selecting tofu saves 0.4 gallons of water, while
selecting beef saves zero gallons of water. In reality, it takes
nearly 450 gallons of water to produce a quarter-pound of
beef, so the framing of “water saved” produces results that
fail to account for this difference.17
6Emissions reduction targets
There is growing consensus on the need for more focus on Companies have made notable progress on setting GHG
reducing emissions and managing climate risk in agriculture, targets: all six target companies have now publicly stated they
forestry, and other land use (AFOLU) sectors. Collaborative will set or have already set global GHG reduction targets. Five
investor engagement initiatives on climate change such as the of the six QSRs have now set or committed to setting best-
Climate Action 100+ and Transition Pathway Initiative that practice emissions reduction targets approved by the Science-
have focused on certain high-emitting sectors, such as energy, Based Targets initiative (SBTi) that would align their businesses
transport and heavy industry, have begun to expand their with the Paris Agreement’s goal to limit global temperature rises
coverage to the food and beverage sector broadly. to well below 2°C.
However, until recently, there was limited standardised • At the start of this engagement in January 2019, McDonald’s
guidance available for companies to account for emissions was the only company to have already set an SBT.
from livestock production and land use change. Now, standard
• In April 2021, Yum! Brands announced that it has set an SBT
setters are releasing more agriculture-specific guidance: the
consistent with a 1.5-degree warming pathway. The company
Science Based Targets initiative (SBTi) is developing guidelines on
now has the most ambitious climate target among its peers
GHG target-setting for the forests, land, and agriculture sectors,
in this engagement. Yum! Brands has committed to reduce its
while the GHG Protocol is developing new guidance on accounting
absolute Scope 1 and 2 emissions by 46% by 2030 from 2019
for emissions from animal products and land use change.18
levels. It will reduce its Scope 3 emissions by 46% during the
Addressing emissions reduction in livestock supply chains same timeframe on a per-restaurant basis for franchisees and a
is crucial for quick-service restaurants, as this is where the per-metric ton basis for beef, poultry, dairy and packaging. The
majority of their emissions arise from. In 2020, RBI completed a company also pledged to achieve net-zero emissions by 2050.19
lifecycle assessment of food, beverage, and packaging categories
• In April 2020, Chipotle committed to set a science-based
to assess carbon, water, and waste impacts, and measured its
target. The company specified that it aims to have its target
Scope 1, 2, and 3 emissions. The company found that Scope 3
validated by the SBTi by the end of 2021. As a result, the
emissions account for >99% of its total footprint. Of its Scope 3
company moved up its target date for the measurement of its
emissions, franchisee energy makes up 15%, and purchased goods
Scope 3 emissions from 2025 to 2021.20
and services comprise 82% – and its key proteins, beef, chicken
and dairy, account for 67% of total Scope 3 emissions. • In February 2021, Domino’s announced that it intends to
establish science-based targets to reduce “the Company’s
total contribution to climate change” within the next one to
Figure 1: RBI’s reported Scope 3 emissions, including emissions
three years.
specifically from beef, chicken and dairy sourcing
• In April 2021, Wendy’s announced that by the end of the
year it intends to conduct a lifecycle assessment of its Scope
99% OF TOTAL FOOTPRINT ARE SCOPE 3 EMISSIONS 3 emissions and commit to the SBTi to begin developing a
science-based target inclusive of Scope 3 emissions. The
company aims to have the target validated by the SBTi by the
82% = PURCHASED GOODS AND SERVICES end of 2023.21
• RBI made considerable internal progress on climate action
67% = BEEF, CHICKEN AND DAIRY SOURCING throughout 2020 and disclosed it will soon set global GHG
reduction targets – though it is not yet clear whether the
targets will be set in accordance with the SBTi. The company
acknowledges the importance of reducing emissions from
livestock production, noting there is a “clear opportunity”
to address emissions in this category.22 Consequently, it is
likely that the company’s upcoming GHG target will address
agricultural emissions in Scope 3.
7Figure 2: Company progress on setting science-based targets and forecasted progress by end-2021 based on public disclosures
Companies’ current progress on SBTs
Statement Statement Set
of intent of intent Statement Formalised Set Set Set 1.5-degree
to set to set of intent to commitment 2-degree WB2C 1.5-degree SBT and
Scope 1+2 Scope 1+2+3 set SBTs to SBTi SBT SBT SBT net-zero
targets targets commitment
Expected changes by end-2021
CASE STUDY: CHALLENGES OF IMPLEMENTING AND ACHIEVING SBTs
At the start of this engagement in January 2019, McDonald’s The need to take new methodologies into account presents
was the only company to have already set an SBT. In 2018, it challenges for companies currently working towards SBTs.
committed to reduce Scope 1 and 2 emissions by 36% by 2030 McDonald’s notes that its latest progress figures against its
from a 2015 base year. It also set a Scope 3 target, committing Scope 1 and 2 target show a lower reduction than previously
to a 31% reduction in emissions intensity (per metric ton of reported, as it had to update its data and methodology
food and packaging) across its supply chain by 2030 from 2015 with new best practice guidance.23 The company expects its
levels. Going forward, investors will be scrutinizing the scope progress figures may change again in the future as data quality
and implementation of these targets. and methods are enhanced.
According to the SBTi target rules, companies must re- Regarding its Scope 3 target, McDonald’s reports that so far it
evaluate their targets every five years, meaning McDonald’s has only achieved 2% of the required reduction in emissions
will be re-evaluating its target in 2023. Investors will be keen intensity. The latest Scope 3 data refers to its 2019 performance
to see McDonald’s build on its leading position. SBTi’s new – just one year after the target was set, with 11 years remaining
Forests, Land and Agriculture criteria and guidance will be to the target achievement date in 2030. McDonald’s indicated
available by the end of 2021, and investors will be interested that it “remains confident that [it] has the right strategy in
to see if companies operating in this sector take the new place”, emphasising the importance of supplier engagement
sector-specific guidance into consideration so that emissions programs to achieve its supply chain targets.
from land-use change and animal production are adequately
measured and reduced.
8TCFD-aligned scenario analysis
Rapidly increasing public support for assessing and reporting The food sector is falling behind: A review conducted by
on climate risks has, so far, not resulted in increased disclosure. the TCFD found that, within the agriculture, food, and forest
The Task Force for Climate-related Financial Disclosures (TCFD) products sector, the percentage of disclosures relating to
issued recommendations in 2017 to help companies disclose strategy for climate-related risks and opportunities fell by 7%
supplementary data to enable financial markets to better between 2017 to 2019. The review further noted that disclosures
understand climate-related financial risks and opportunities. As against the ‘resilience of strategy’ indicator were particularly
of October 2020, over 1,500 companies and financial institutions low for the sector and did not show any improvement across
had declared their support for the TCFD recommendations. three years from 2017 to 2019. The results also show that the
Despite this strong public support, an assessment of more than sector is lacking in governance-related disclosures.
1,700 publicly-listed banks, insurance firms, and corporations
found that disclosures of TCFD-aligned information increased
by only 6% between 2017 and 2019.24
Figure 3: TCFD agriculture, food, and forest products sector review
Recommended Percent of companies that disclose information
Recommendations disclosure Pt change 2017-2019 aligned with TCFD recommended disclosures
Governance a) Board oversight 9 2017 11%
2018 13%
2019 20%
b) Management’s role 3 2017 18%
2018 14%
2019 21%
Strategy a) Risks & opportunities -7 2017 48%
2018 49%
2019 41%
b) Impact on organisation 3 2017 31%
2018 31%
2019 35%
c) Resilience of strategy 0 2017 1%
2018 1%
2019 1%
Risk management a) Risk ID and assessment 14 2017 7%
procedures 2018 12%
2019 21%
b) Risk management 9 2017 17%
procedures 2018 17%
2019 26%
c) Integration into 10 2017 4%
overall risk management 2018 7%
2019 14%
Metrics and targets a) Climate-related metrics -1 2017 35%
2018 37% Percentage
2019 35% of companies
b) Scope 1, 2, 3 3 2017 25% that disclosed
GHG emissions 2018 25% information
2019 28% aligned
with TCFD
c) Climate-related targets 6 2017 32%
recommended
2018 33%
disclosures in
2019 38%
2019
Source: TCFD. 2020. 2020 Status Report: Task Force on Climate-related Financial Disclosures. Available at: https://assets.bbhub.io/company/sites/60/2020/09/2020-TCFD_Status-Report.pdf
9As well as being a major contributor to GHG emissions, Implementation Aids
livestock production (and agriculture as a whole) is extremely
vulnerable to climate risk. According to the Intergovernmental In October 2020, the TCFD published guidance for
Panel on Climate Change (IPCC), animal agriculture systems scenario analysis for non-financial companies, intended
will suffer increased costs of water, feed, and infrastructure to assist these companies in using climate-related
damage due to extreme weather events, as well as lower animal scenario analysis.
productivity. Globally, rangeland livestock is predicted to drop
by 7-10% in a 2°C warming scenario, with “considerable economic In addition, the WBCSD in April 2020 published a report
consequences for many communities and regions”,25 says the IPCC on the food, agriculture, and forest products industry,
Special Report on Climate Change and Land (2019). Companies providing commentary on the key areas of the TCFD’s
that rely on livestock products are at risk of lower product recommendations that is supported by examples of
availability and therefore higher costs in protein supply chains. In effective practice consistent with the recommendations.
total, the Coller FAIRR Climate Risk Tool identifies seven direct The report is based on members’ individual experience of
risks that impact the profitability of the meat sector: the growth implementation within the sector.
of meat substitutions; a CO2 price on meat; increased veterinary
costs; a CO2 price on electricity; increased feed costs; increased
electricity costs and increased mortality rates in livestock. Company progress
Despite agriculture’s high exposure to climate risks, companies • As of 2019, McDonald’s was the only company in this
in this industry are only just beginning to conduct scenario engagement to publicly commit to conducting a scenario
analyses to better understand how these issues may impact analysis within the next two years.26 This commitment was
their business operations and supply chains. QSRs can learn disclosed in 2019, suggesting the company may be ready to
from peers and suppliers that have begun this process and disclose a completed analysis in 2021.
use their findings to help inform their own analyses: see the
• In 2020, a second company – Yum! Brands – committed to
Coller FAIRR Protein Producer Index: GHG Emissions Report for
conducting a qualitative and/or quantitative climate-related
discussion of Brazilian beef producer Marfrig and New Zealand
scenario analysis in the next two years.27
dairy producer Fonterra’s climate scenario analyses. The common
theme of regulation and carbon taxes in both analyses implies • The remaining four companies – Wendy’s, Chipotle, Domino’s,
that the cost of raw materials from agricultural suppliers may and RBI – have yet to publicly commit to conducting a climate
increase and impact companies’ profit margins. scenario analysis based on TCFD guidelines.
10Supply chain water use and quality
Despite making substantial progress towards setting emissions • Yum! Brands has not yet set water use or quality targets for
reduction targets over the last year, efforts towards mitigating its supply chain. The company has stated it will continue to
risks related to water scarcity and pollution from meat supply conduct global water risk assessments of its restaurants and
chains have been more limited. Domino’s and Wendy’s have yet franchisee locations every two years using the WRI Aqueduct
to disclose if they are conducting water risk assessments of their tool. The company also disclosed that it assesses water risk
animal protein supply chains – a foundational step in prioritizing in its supply chain through its Enterprise Risk Management
which vulnerabilities and regions should receive the most framework every year, but does not discuss the results. Yum!
attention. (Wendy’s recently disclosed that it has undertaken a Brands states that as a result of its supply chain water risk
water risk assessment of its Company-operated restaurants.) monitoring, purchasing teams are able to switch to alternative
suppliers if water availability impacts commodity supply.
Nonetheless, several of the focus companies have undertaken
However, it does not discuss how it is measuring or improving
efforts to promote sustainable agricultural practices that
water use and quality issues in its supply chain.33
can address emissions, water availability, and water quality
simultaneously: These projects indicate that the QSRs recognize that
promoting more sustainable agricultural practices can help
• RBI has yet to disclose specific water use or quality
them address emissions and water risks simultaneously.
performance data or targets. However, it measured its
By promoting agricultural practices such as cover cropping,
supply chain water use for the first time through a lifecycle
reduced tillage, and fertilizer optimization, companies can support
assessment conducted in 2020, which will inform its
projects that improve soil’s water retention, reducing nutrient
responsible sourcing strategy going forward.28
runoff and enhancing resilience to droughts and floods, while also
• Burger King – a subsidiary of RBI – partnered with Cargill and reducing agricultural emissions. These partnerships between the
the World Wildlife Fund to launch a grasslands restoration QSRs and meat processors also demonstrate an encouraging trend
program in the Northern Great Plains. The program aims of collaboration across the animal protein value chain, which will
to convert 8,000 acres of marginal cropland to ecologically be critical to ensuring more sustainable production.
diverse grasslands over the next three years.29
It is important to recognize that these programs – at their
• McDonald’s and RBI partnered with Cargill, Target, and the current scale – are not likely to sufficiently mitigate physical
Nature Conservancy on a pilot program intended to advance risks to the meat supply chain from droughts, flooding, and
the implementation of soil health practices amongst Nebraska regulatory and reputational risks related to water pollution.
farmers. The project aims to impact 100,000 acres of row Several of the partnerships described above focus on the
crops over five years.30 Northern Great Plains region of the US. While this is an important
region for cattle grazing, meat processors are increasingly
• McDonald’s, Cargill, and the Walmart Foundation invested
vulnerable to water stress in other critical agricultural regions.34
over $6 million in the Ranch Systems and Viability Planning
Network – an initiative led by the World Wildlife Fund that
supports the use of sustainable agricultural practices in the
Northern Great Plains.31
• In 2020, Chipotle amended its supplier audit form to include
questions about water management. The company also
committed to conduct an updated water risk assessment of
its restaurants and supply chains this year, indicating that data
collected from the assessments will inform future goals on
water management.32
11Supplier policies
Despite progress on GHG target-setting, companies are not • One QSR company privately disclosed that it recognises this
yet disclosing supplier policies with specific climate or water as an important next step and will expand its internal systems
requirements, verification mechanisms, or non-compliance to capture this information.
protocols.
• McDonald’s now asks 108 suppliers (almost double from 55
• This year, Wendy’s committed to responsibly sourcing its top in 2018) to report to CDP Climate and Forests through the
10 priority food categories by 2030. Beef, chicken, pork, dairy, CDP Supply Chain Platform. This now includes all globally-
and eggs are included as priority food categories. Wendy’s managed beef, chicken, dairy and cheese suppliers. However,
has elected to craft its own definition of responsible sourcing it is not clear what proportion of total procurement is
for each ingredient, and is in the process of developing globally managed (as opposed to locally managed). This is
environmental and social criteria for these definitions. Though a significant step forward, but it should be followed by the
water use and pollution criteria are likely to be included, this implementation and publication of specific climate and water
has yet to be confirmed. supplier requirements for all protein suppliers.
• Yum! Brands now includes some language on environmental Generally, supplier requirements that are currently disclosed
performance in its Supplier Code of Conduct. This document continue to focus on animal welfare, food safety, labour rights,
states that suppliers must have systems in place to ensure and regulatory compliance, with less emphasis on suppliers’
the safe management of waste, air emissions, and wastewater emissions, water, and land-use footprints.
discharge. The company also states it expects suppliers to
monitor and report performance against environmental
improvement targets and demonstrate year-on-year
improvements. But this does not appear to be a requirement
12Evaluation framework to assess risk management
Dimension Indicator Question
Board oversight Board briefings Is the board briefed at least once a year by management on the company’s strategies for mitigating
environmental risks associated with its meat and dairy supply chains?
Risk management Have company representatives communicated the physical/transition risks from climate change and
water on commodity sourcing to the board?
Supplier policy OVERALL EXPECTATIONS
Issue coverage Does the company have a publicly available supplier policy that has clear requirements on the
climate, deforestation, water use and quality impacts of its commodity suppliers?
Supplier assurance Does the company have a supplier monitoring and verification system that ensures that direct and
indirect suppliers meet the company’s environmental requirements?
Non-compliance protocol Does the policy include a non-compliance protocol with specific criteria (e.g., violations of
no-deforestation pledges or major pollution incidents) that would trigger the suspension or
termination of contracts and that facilitates the development of time-bound action plans for
suppliers to return to compliance?
SPECIFIC REQUIREMENTS
Climate
Major sources: Does the supplier policy specify that suppliers will address all major emissions sources, including
Includes emissions those related to land use change and deforestation, enteric emissions from animals, and emissions
from manure, enteric from manure and chemical fertilizers?
fermentation, fertilizers
Does the supplier policy ask direct suppliers to measure, report and reduce the GHG emissions
and land use change
associated with their direct operations and agricultural supply chains?
Water
Major sources: Includes Does the supplier policy specify that supplier will address all major sources of water pollution and
pollution and waste in feed, waste in the animal protein supply chain, including slaughtering and processing activities, animal
farming, CAFOs & processing production (CAFOs), and feed production?
Report Does the supplier policy ask direct suppliers to measure, reduce (beyond regulatory compliance
levels) and report on the water quantity and quality impacts of their direct operations and
agricultural supply chains?
Context-based Does the supplier policy encourage suppliers to set context-based water targets?
water targets
Forests Does the company have a time-bound and quantifiable zero-deforestation/conversion-free policy
that covers the entire supply chain of soy, cattle and palm commodities?
Targets Climate
Scope 1 + 2 target Has the company set a time-bound, quantitative reduction target for Scope 1 and Scope 2 GHG
emissions? Is it a science-based target?
Scope 3 target Has the company set a time-bound, quantitative emissions reduction target that explicitly addresses
Scope 3 emissions? Is it a science-based target?
Water
Direct operations Has the company set time-bound quantitative targets to reduce water use in direct operations?
Suppliers Has the company set a time-bound target that explicitly addresses water impacts in its feed and
animal farming supply chain?
Risk assessment & Water risk assessment
scenario analysis
Direct operations Has the company conducted a water risk assessment across its direct operations?
Suppliers Has the company conducted a water risk assessment of suppliers of major commodities?
Scenario analysis/TCFD
Committed to conducting Has the company committed to undertaking and publishing a climate scenario analysis in line with
TCFD recommendations?
13Company benchmarking This evaluation is based primarily on public disclosures.
During the dialogues, companies have privately disclosed
various levels of improvement against this framework. These
improvements, however, are not necessarily reflected in this
evaluation due to the timing of public disclosures.
Dimension Indicator CMG DPZ MCD QSR WEN YUM
Board oversight Board briefings YES PARTIAL PARTIAL PARTIAL YES PARTIAL
Risk management YES YES PARTIAL DNF YES PARTIAL
Supplier policy OVERALL EXPECTATIONS
Issue coverage PARTIAL DNF PARTIAL PARTIAL PARTIAL PARTIAL
Supplier assurance YES DNF PARTIAL PARTIAL PARTIAL PARTIAL
Non-compliance protocol PARTIAL DNF PARTIAL PARTIAL PARTIAL PARTIAL
SPECIFIC REQUIREMENTS
Climate
Major sources DNF DNF DNF DNF PARTIAL DNF
Report DNF DNF PARTIAL DNF DNF DNF
Water
Major sources PARTIAL DNF PARTIAL DNF PARTIAL DNF
Context-based water targets DNF DNF PARTIAL DNF DNF DNF
Report PARTIAL DNF PARTIAL DNF PARTIAL DNF
Forests
DNF PARTIAL PARTIAL YES PARTIAL PARTIAL
Targets Climate
Scope 1 + 2 target PARTIAL PLANNED YES PLANNED PLANNED YES
Scope 3 target PLANNED PLANNED YES PLANNED PLANNED YES
Water
Direct operations PLANNED DNF PARTIAL DNF YES YES
Suppliers PLANNED DNF DNF DNF DNF DNF
Risk assessment & Water risk assessments
scenario analysis
Direct operations PLANNED DNF YES DNF YES YES
Suppliers PLANNED DNF YES DNF DNF PARTIAL
Scenario analysis/TCFD
Committed to conducting DNF DNF YES DNF DNF YES
DNF = Did Not Find
CMG = Chipotle Mexican Grill; DPZ = Domino’s Pizza; MCD = McDonalds; QSR = Restaurant Brands International; WEN = Wendy’s; YUM = Yum! Brands
14Next steps for engagement
Supply chain water use and quality TCFD-aligned scenario analysis
While several QSRs have formed partnerships with meat As of April 2020, none of the six target companies have
processors, the QSRs have yet to set strong targets related completed and disclosed a climate scenario analysis aligned
to the water use or quality of their meat and dairy supply with TCFD recommendations. Now that all companies have
chains. Strong water targets should focus on absolute as set or are in the process of setting GHG targets, companies
opposed to normalized reductions, while considering the should push forward on assessing climate risks – especially given
local context and focusing the most aggressive reductions in livestock production’s high vulnerability to these impacts.
use or discharge in watersheds that are the most impaired. To
determine which watersheds are both critical to their meat
sourcing and are facing high stress conditions, companies should Investors: register your interest
conduct water risk assessments leveraging the many third-party
tools and resources available. Ceres and FAIRR look forward to supporting investors
to continue dialogues with these QSRs. Investors may
As the QSRs begin to implement efforts to meet their emissions register their interest in supporting the third phase of
reduction targets, they have an opportunity to address water the Global Investor Engagement on Meat Sourcing by
use and quality simultaneously. By promoting agricultural completing this form.
practices, such as cover cropping, reduced tillage, and fertilizer
optimization, the farmers that ultimately supply the QSRs can
also improve the water retention of their soil, reducing nutrient
runoff and enhancing their resilience to droughts and flooding.
INVESTORS COMBINED ASSETS
COORDINATED BY
FOCUS COMPANIES
15Endnotes
1 Net Zero Asset Managers Alliance. Available at: https://www.netzeroassetmanagers. Carbon Removals and Land Sector Initiative”. Available at: https://ghgprotocol.org/
org/; UNEPFI. UNITED NATIONS-CONVENED NET-ZERO ASSET OWNER ALLIANCE. blog/update-greenhouse-gas-protocol-carbon-removals-and-land-sector-initiative
Available at: https://www.unepfi.org/net-zero-alliance/ 19 Yum! Brands. Planet. Available at: https://www.yum.com/wps/portal/yumbrands/
2 UK Government (2020) “Chancellor sets out ambition for future of UK financial ser- Yumbrands/citizenship-and-sustainability/planet
vices.” Available at: https://www.gov.uk/government/news/chancellor-sets-out-ambi- 20 Chipotle 2020 Sustainability Report. Available at: https://www.chipotle.com/about-
tion-for-future-of-uk-financial-services us/sustainability
3 Commodity Futures Trading Commission (2020) “CTFC’s Climate-Related Market Risk 21 Wendy’s 2020 Corporate Responsibility Report. Available at: https://www.wendys.
Subcomittee Releases Report”. Available at: https://www.cftc.gov/PressRoom/Press- com/sites/default/files/2021-04/Wendys-2020-CSR-0419_FINAL.pdf
Releases/8234-20 22 Restaurant Brands International. Sustainability – Planet – Climate Action. Available at:
4 Federal Reserve (2021) “FEDS Notes: Climate Change and Financial Stability.” https://www.rbi.com/English/sustainability/planet/climate-action/default.aspx
Available at: https://www.federalreserve.gov/econres/notes/feds-notes/cli- 23 McDonald’s Corporation. CDP Climate Change 2020.
mate-change-and-financial-stability-20210319.htm 24 TCFD (2020) “2020 Status Report: Task Force on Climate-related Financial Disclosures”.
5 https://www.jdsupra.com/legalnews/biden-administration-begins-1601137/ Available at: https://assets.bbhub.io/company/sites/60/2020/09/2020-TCFD_Sta-
6 https://www.theguardian.com/environment/2019/dec/18/epa-sued-weak-stand- tus-Report.pdf
ards-allow-slaughterhouses-pollute-waterways-meat-processing 25 IPCC (2019) “Special Report on Climate Change and Land”. Available at: https://www.
7 https://www.booker.senate.gov/news/press/as-pandemic-exposes-major-weakness- ipcc.ch/srccl/
es-in-meatpacking-industry-sen-warren-rep-khanna-cosponsor-sen-bookers-farm- 26 McDonald’s Corporation, CDP Climate Change 2019.
system-reform-act-to-fix-broken-system 27 Yum! Brands, CDP Climate Change 2020. Available at: https://www.yum.com/wps/
8 McDonald’s Corporation, CDP Climate Change 2020 wcm/connect/yumbrands/ac6d45b7-5ef1-4356-b986-8f94db104a82/2020-Climate-
9 Yum! Brands, CDP Climate Change 2020 Change-090420V2.pdf?MOD=AJPERES&CVID=nhLFcq3
10 https://www.unepfi.org/publications/banking-publications/beyond-the-horizon/ 28 Restaurant Brands International (2021) “Restaurant Brands for Good 2020”. Available at:
11 Kate A Brauman et al 2020 Environ. Res. Lett. 15 105018 https://s26.q4cdn.com/317237604/files/doc_downloads/2021/03/031121-RB4G-ENG-
12 Wendy’s Notice of 2021 Annual Meeting & Proxy Statement LISH.pdf
13 Wendy’s 2020 Corporate Responsibility Report. Available at: https://www.irwendys. 29 https://www.cargill.com/2020/world-wildlife-fund-joins-the-walmart-foundation,-
com/esg/overview/default.aspx cargill,-mcdon
14 https://www.squaredealblog.com/homewendys/2020-annual-meeting-of-stockholders 30 https://www.cargill.com/2020/the-nature-conservancy-cargill-mcdonalds-and-tar-
15 Domino’s Pizza Inc. Notice of 2021 Annual Meeting of Shareholders and Proxy State- get-unite
ment 31 https://www.cargill.com/2020/world-wildlife-fund-joins-the-walmart-foundation,-
16 https://newsroom.chipotle.com/2021-03-04-CHIPOTLE-ANNOUNCES-EXECU- cargill,-mcdon
TIVE-COMPENSATION-METRICS-TIED-TO-SUSTAINABILITY-GOALS 32 Chipotle 2020 Sustainability Report. Available at: https://www.chipotle.com/about-
17 https://www.watercalculator.org/footprint/meat-portions-900-gallons/18 us/sustainability
Science Based Targets Initiative. Sector Research. Available at: https://sciencebased- 33 Yum! Brands. CDP Water Security 2020.
targets.org/sectors; GHG Protocol (2020) “Update on Greenhouse Gas Protocol 34 Kate A Brauman et al 2020 Environ. Res. Lett. 15 105018
1617
Ceres is a nonprofit organization working with the most The FAIRR Initiative is a collaborative investor network,
influential capital market leaders to solve the world’s greatest founded by Jeremy Coller, with a membership of $33 trillion
sustainability challenges. Through our powerful networks assets under management. FAIRR works with institutional
and global collaborations of investors, companies and investors to define the material ESG issues linked to intensive
nonprofits, we drive action and inspire equitable market- livestock and fish farming systems and provide them with the
based and policy solutions throughout the economy to build tools necessary to integrate this information into their asset
a just and sustainable future. For more information, visit stewardship and investment decisions. This includes the Coller
ceres.org and follow @CeresNews. FAIRR Index, the world’s first comprehensive assessment of
the largest global animal protein companies on environmental,
social and governance issues. Visit www.fairr.org and follow
@FAIRRinitiative.
CONTACT DETAILS CONTACT DETAILS
Kirsten James Aarti Ramachandran
Director, Water Program Director, Research and Engagements
james@ceres.org Aarti.Ramachandran@fairr.org
Jacob London Faazi Adam
Manager, Investor Engagement, Water Research and Engagement Manager
18You can also read